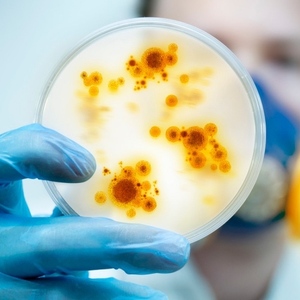

记者 |
近日关于新冠肺炎无症状感染者是否会引发我国疫情反弹,成为社会广泛关注的热点问题。中国疾控中心首席流行病学家吴尊友最新发表的论文指出,在当前我国已基本控制了国内新冠肺炎疫情的情况下,社会层面不可能存在数量可观的无症状感染者。
这篇发表在《中华流行病学杂志》上的论文题为《新型冠状病毒肺炎无症状感染者在疫情传播中的作用与防控策略》。
论文表示,近期我国报告现有病例中,无症状感染者人数和比例明显增加,说明目前防控措施能够及时捕获更多处于感染早期的人。
2020年4月1日起,国家卫健委开始在每日疫情通报中公布无症状感染者报告、转归和管理情况。据最新数据,4月10日,31个省(自治区、直辖市)和新疆生产建设兵团报告新增无症状感染者34例,其中境外输入无症状感染者7例,目前尚在医学观察的无症状感染者为1092例(境外输入338例)。
国家卫健委给新冠肺炎无症状感染者的定义是:无临床症状,呼吸道等标本新型冠状病毒病原学或血清特异性IgM抗体检测阳性者。吴尊友在论文中指出,无症状感染者有两种可能,一种是感染者始终不发病,即真正的无症状感染者,医学上通常称为隐性感染者。另一种实质是疾病发展过程中的过渡性无症状感染者,即潜伏期患者在出现临床症状前的短暂过程。

“无症状感染者由于没有症状,如果不开展主动检测,是难以发现的。”吴尊友认为,现有病例中无症状感染者的比例,更多地体现了发现早期病例的能力,尤其是尚未出现症状的感染者。换句话说,检测越早,无症状感染者占比越高。
国内最早发现无症状感染者现象是在广东深圳。2020年1月17日,广东省疾控中心在对输入病例的家庭成员密切接触者开展检测时,发现了2名无症状感染者,经跟踪观察,结果1名转为确诊病例,1名为隐性感染者。
据宁波市疾控中心传染病防治所陈奕等发表的研究报告,无症状感染者占总感染人数的比例为15.7%(30/191),其中,输入的新冠病毒感染者中,无症状感染者占13.6%(8/59),在当地传播的续发感染者中无症状感染者占比16.7%(22/132)。另据南方某省报告,已康复及尚在医学观察的无症状感染者占全部报告病例(确诊病例1490例和无症状感染者140例)的比例为8.6% (140/1630)。
对于潜伏期无症状感染者的传染性,目前公开发表的科学论文显示,确诊病例在潜伏期无症状阶段也可以造成传播。而隐性感染无症状感染者是否也有传染性?
吴尊友认为,一般来说,其传染性应该没有潜伏期无症状感染者强,也没有显示临床症状的确诊病例强。一方面,隐性感染无症状感染者感染的病毒量或者病毒在体内复制的量,没有潜伏期无症状感染者或确诊病例多。另一方面,没有咳嗽等症状,也减弱了隐性感染无症状感染者的传染性。
社会上是否还存在大量的无症状感染者未被发现,是否会成为我国第二次流行的潜在风险?吴尊友论文认为,在当前我国基本控制了国内新冠疫情的情况下,特别是全国范围内都全面实施了至少2两周以上的居家隔离。如果有人在隔离前就感染了,那么,超过一个最长潜伏期后他们应该已经发病,即使是无症状感染者,也会因2周以上隔离而不会继续带病毒。因此,在我国当前形势下,社会层面不可能存在数量可观的无症状感染者。
从全国总体疫情来看,超过85%病例都是能够找到明确传染来源,那些没有找到传染来源的,部分是流行病调查质量问题,或者病例不配合,或者由于各种原因隐瞒了发病经过,或者回忆不清,部分可能是无症状感染者传播。这个数据也提示,由无症状感染者造成的传播,对我国新冠肺炎疫情的总体影响是有限的。
不过,吴尊友也指出,尽管我国基本控制了新冠肺炎疫情,但疫情反弹的风险很大,防范疫情反弹还面临着诸多挑战,“应该看到,我国14亿人口感染总人数不到10万人,绝大多数人对新型冠状病毒还是易感的。一旦传染源引入,如果未能及时发现或控制,则难以避免疫情反弹。”